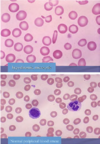
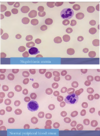
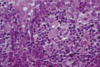
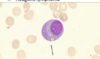

All Topics (with details-not just images,tx,etiologies, more!) Flashcards
Use this if you want to study more details like epidimology, location, clinical manifestations) (1726 cards)
What are the two types of Odontogenic Cysts?
Inflammatory
or
Developmental
List the type of Inflammatory cysts
(4)
- Periapical (radicular)
- Residual periapical
- Buccal bifurcation
- Paradental
List the types of Developmental Cysts?
(9)
‐ Dentigerous
‐ Eruption
‐ Gingival cyst of newborn
‐ Gingival cyst of adult
‐ Lateral periodontal
‐ Glandular odontogenic
‐ Odontogenic keratocyst
‐ Orthokeratinized odontogenic
‐ Calcifying Odontogenic
All of the following are histologically the same because they are all what?
-Periapical (radicular)
‐ Residual periapical
‐ Buccal bifurcation
‐ Paradental
‐ Dentigerous
‐ Eruption
‐ Gingival cyst of newborn
‐ Gingival cyst of adult
squamous epithelial lined cysts
What are the sources of epithelium
within the jaw bone ?
(6 sources)
▪ Epithelial rests of Malessez
▪ Reduced enamel epithelium
▪ Fissural cysts – when 2 pieces of bone come together
▪ Odontogenic cysts
▪ Epithelial component of odontogenic tumors
▪ Salivary gland inclusions – rare, incorporated in development
radicular cyst, inflammatory cyst are other names for
Periapical Cysts
▪ The most common cyst of the jaws
Periapical Cysts
Periapical Cysts
Demographic and location
▪ Any age (peak in 3rd ‐ 6th decades, rare in 1st decade)
▪ No sex predilection
▪ MX > MD (anterior MX most common)
Tooth vitality and Periapical Cysts
- Involved tooth usually non‐vital/non‐responsive with thermal and electric pulp testing
- Should test vitality of tooth if see radiolucency in apex\
- If tooth vital, and still see radiolucency ► should do biopsy
Periapical Cyst
(Radiographic)
- Usually appears as well‐circumscribed periapical radiolucency with widening of the PDL space and/or loss of lamina dura
- Typically small (< 1 cm) but can grow to large dimensions if left untreated
- Radiographic findings can NOT be used for definitive diagnosis
Why the Radiographic findings of Periapical Cyst can NOT be used for definitive diagnosis?
‐ similar appearance with:
- periapical granuloma
- odontogenic tumors
- early COD {Cemento Osseous Dysplasia}
Lateral radicular cyst appears on the lateral surface of the root of a non‐vital/non‐responsive tooth
‐ A differential for which cyst?
lateral periodontal cyst
What is this radiographic finding?

Periapical Cysts
►Would need to test both teeth for vitality.
What is this radiographic finding?

Periapical Cyst
What is this radiographic & clinical findings?

Periapical cyst
shows inflammation at site
abscess developed fistula tract thru
soft tissue. Pt will have pain until
pressure is released
The wall of which cyst?

Periapical Cyst
Open clear areas = Cholesterol clefts where fat
used to be. Multinucleated cells (purple dots)
trying to break down cholesterol
What is this and what is it associated with?

keratin pearl – can be associated w/SCC
What are these radiographic findings?

Residual Cysts
What is the radiographic finding?

Residual Cyst
Periapical Cyst
treatment
- endodontic therapy or extraction of involved teeth
- larger lesions may require biopsy along with endodontic therapy
- lesions which fail to resolve should be biopsied
- follow-up at 1-2 years
Residual Cyst
Etiology
- After tooth extracted, not properly cleaned ► the residual cells of the cyst lining and inflammatory cells continue to proliferate
- Has to be at site where tooth was previously removed
Residual Cyst
Radigraphically
- well defined round to oval radiolucency in the site of a previous extraction
Residual Cyst
Histologically is identical to which cyst?
- identical to the radicular cyst (periapical cyst)
- Should biopsy to rule out other causes